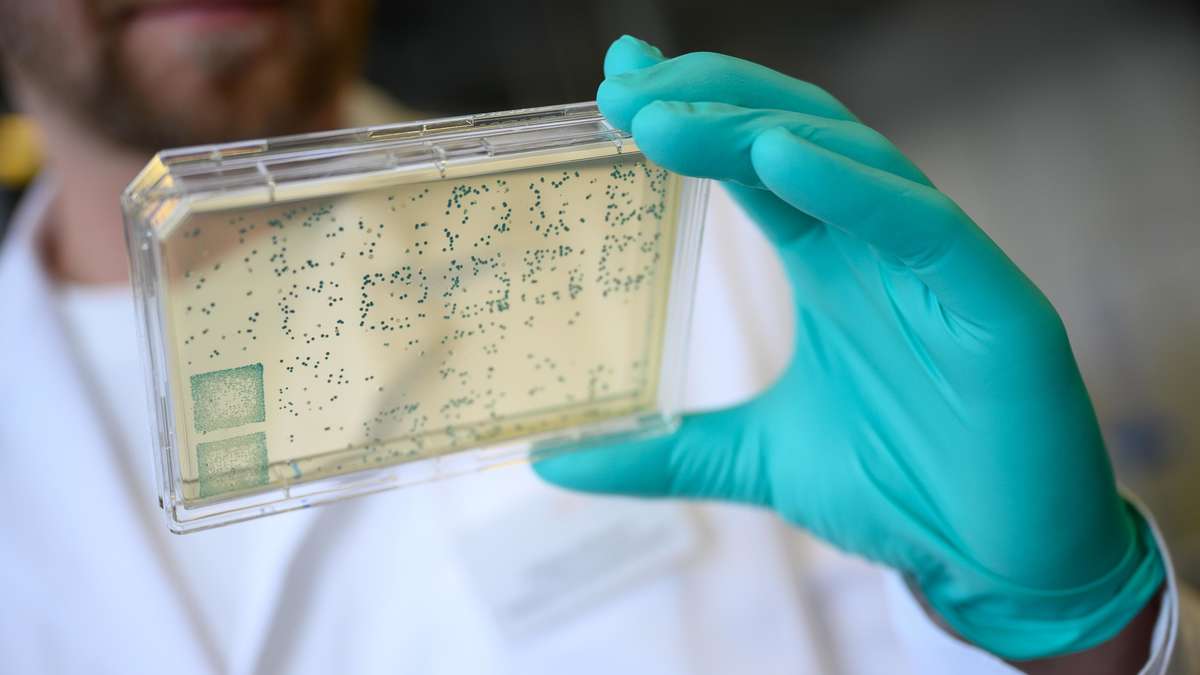

Coronavirus: Durchbruch! Forscher entdecken den Ursprung von Sars-CoV-2 – und haben jetzt eine Nachfrage
4 min read
In einer Studie identifizierte ein internationales Forschungsteam den Ursprung des neuartigen Coronavirus Sars-CoV-2. Tiere haben es seit vielen Jahren.
- Das Coronavirus Pandemie * hat weltweit viele Opfer gefordert.
- Ein internationales Forschungsteam aus dem Pennsylvania Staatsuniversität untersuchten den Ursprung des neuartigen Coronavirus * SARS-CoV-2.
- Tiere tragen das Coronavirus seit vielen Jahren an sich.
München / Pennsylvania – Die Coronavirus Pandemie hat weltweit viele Opfer gefordert. Mehr als 19 Millionen Menschen waren mit der Krankheit infiziert Covid-19verursacht durch das neuartige Coronavirus SARS-CoV-2 Verursacht. Über 700.000 der Infizierten starben weltweit. Ein internationales Forschungsteam aus dem Pennsylvania Staatsuniversität hat jetzt ein schwestervirus von in einer studie SARS-CoV-2 entdeckt. Beide Viren scheinen denselben Ursprung zu haben.
Im Video: Corona – Zahlen steigen auf mehr als 1.000 Infektionen pro Tag
Coronavirus: Fledermäuse und Pangoline, die als Wirte vermutet werden
Bisher galt es als sicher, dass das neue Coronavirus sprang von einem Tier zu einem Mann. In Fachkreisen spricht man diesbezüglich von a Zoonose. Anfangs waren Fledermäuse, das heißt Fledermäuse, Fruchtfledermäuse und dergleichen werden als anfängliche Wirte angenommen.
Auch ein PangolinEs wurde angenommen, dass der Pangolin der Wirt ist, weil das stachelige Protein von SARS-CoV-2 ähnelt dem Protein einiger in Pangolinen gefundener Coronaviren. Beide Arten können auch an der Zoonose beteiligt sein. Das Virus könnte von sein Fledermäuse auf der Pangoline sprang über und danach von diesem Zwischenwirt zum Menschen kam.
Corona: Internationales Forschungsteam erforscht den Ursprung von Sars-CoV-2
Seit dem Ausbruch war weltweit viel los Coronavirus recherchiert *. Ein internationales Forschungsteam rund um den Infektiologen Maciej Boni des Pennsylvania Staatsuniversität analysierte nun die Gene des Romans Coronavirusum seine Ursprünge rekonstruieren zu können. Die Wissenschaftler veröffentlichten ihre Ergebnisse in einer Fachzeitschrift „Naturmikrobiologie“.
Evolutionäre Ursprünge der SARS-CoV-2-Sarbecovirus-Linie, die für die COVID-19-Pandemie verantwortlich ist – Die Linie, die SARS-CoV-2 verursacht, zirkuliert seit Jahrzehnten unbemerkt bei Fledermäusen
Von Maciej Boni @arambaut @robertson_lab @ LemeyLab et al. https://t.co/hzfyxkD0mw– Alfons López Tena (@alfonslopeztena) 30. Juli 2020
Der Roman Coronavirus Sars-CoV-2 ist ein RNA-Virus. Das genetische Material besteht daher aus dem Biomolekül Ribonukleinsäure. Die Wissenschaftler verglichen die RNA-Sequenzen mit denen anderer Fledermaus-Coronaviren. Sie untersuchten den Grad der Rekombination im Genom dieser Viren, um festzustellen, inwieweit Teile ihres Genoms ausgetauscht wurden.
Der Hauptautor der Studie Gut erklärt: „Coronaviren haben genetisches Material, das stark rekombinant ist, was bedeutet, dass verschiedene Regionen des Virusgenoms aus mehreren Quellen stammen.“ Das machte es schwierig, die Herkunft von zu bestimmen SARS-CoV-2 zu rekonstruieren. „Wir mussten alle diese Regionen identifizieren und ihren Geschichten folgen“, sagt er Infektiologe.
Sars-CoV-2 entwickelte sich wahrscheinlich in Fledermäusen zu einem menschlichen Virus
Die Forscher fanden das heraus SARS-CoV-2 und ein anderer Fledermausvirus mit dem Etikett RaTG13 sind sehr eng miteinander verwandt. Dieser Virus wurde in einem gefunden Hufeisenfledermaus, eine Fledermaus, gefunden etwa 1.600 Meilen entfernt von Wuhan, von wo aus die CoronaPandemie breitete sich zunächst in der Provinz Yunnan wohnte. Die genetische Übereinstimmung der beiden Viren ist enthalten 96 Prozent. Sie stammen daher wahrscheinlich von einem direkten gemeinsamen Vorfahren. SARS-CoV-2 und RaTG13 entwickelt, sowie andere verwandte Coronaviren, in den Hufeisenfledermäusen, aber in zwei verschiedenen Linien.
Zwei ähnliche Coronaviren gefunden in Pangolinen gefunden, gespalten nach der Studie noch vor dem Auftauchen der Sars-CoV-2 / RaTG13Zeile nach unten. Daraus schließen die Forscher, dass der Roman Coronavirus wahrscheinlich nicht in Pangolinen, sondern in Fledermäusen zum menschlichen Virus entwickelt.
Neu #Coronavirus Unbemerkt in Umlauf gebracht # Fledermäuse Seit Jahrzehnten: Studium
Coronavirus: Hufeisenfledermäuse sind der plausibelste Ursprung des SARS-CoV-2-Erregers, Forscher unter der Leitung von Maciej Boni …https://t.co/1nebfQeK8v pic.twitter.com/z9W2SkOJqr
– Wissenschaftsakademie (@SienceAcademy) 4. August 2020
Das Wissenschaftler weisen darauf hin: „Insgesamt deutet unsere Analyse auf Fledermäuse als primäres Reservoir für die Sars-CoV-2-Linie hin.“ Es ist möglich, dass Pangolineoder eine andere noch nicht identifizierte Art diente als Zwischenwirt beim Menschen. „Derzeit sieht es jedoch so aus, als hätte ein Virus, das sich in Fledermäusen entwickelt hat, eine Gruppe von Viren gebildet, die die oberen Atemwege von Menschen und Schuppenflecken infizieren können“, erklären sie Forscher.
Studie: Mehr Fledermaus-Coronaviren könnten sich auch auf den Menschen ausbreiten
Laut der Studie ist das Stichprotein für das Andocken von verantwortlich SARS-CoV-2 an den ACE2-Rezeptoren auf menschlichen Zellen wird durch Rekombination kaum verändert. Das bedeutet, dass diese Struktur der Roman ist Coronavirus macht es zunächst zu einem Krankheitserreger für den Menschen, auch für andere Fledermaus-Coronaviren kann gefunden werden. Diese könnten auch menschliche Zellen angreifen.
Die Forscher rund um den Infektiologen Gut Schließen Sie daher: „Die verschiedenen Stämme, die vom gemeinsamen Vorfahren von Sars-CoV-2 / RaTG13 abstammen, bilden eine Gruppe mit der allgemeinen Fähigkeit, Säugetierzellen zu infizieren. Dies ermöglichte den Übergang zum Menschen, und das konnte wieder passieren. Weil es schwierig und gefährlich ist Erreger zu entdecken, bevor sie ausbrechen, drängen die Wissenschaftler globales Überwachungssystemungewöhnliche Krankheitsgruppen so schnell wie möglich zu identifizieren und die Krankheitserreger zu lokalisieren.
Ärzte warnen vor möglichen Folgeschäden durch die Covid 19-Krankheit – insbesondere an der Lunge. Eine Koronastudie aus Wuhan, China, weist nun in diese Richtung. Das britische Corona-Management scheint alles andere als reibungslos zu laufen. Rund 740.000 Koronatests mussten zurückgerufen werden. (ph) * Merkur.de ist Teil des landesweiten Ippen-Digital-Netzwerks

Unapologetic Alkohol Guru. Zombie-Enthusiast. Typischer Internet-Nerd. Freundlicher Leser. Ergebener Twitter-Maven






